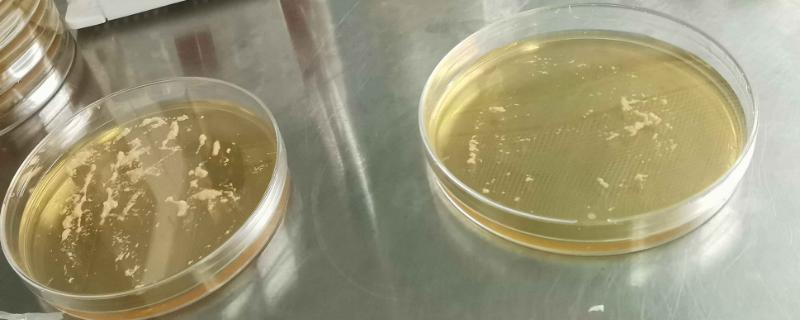
菌种选育的优缺点
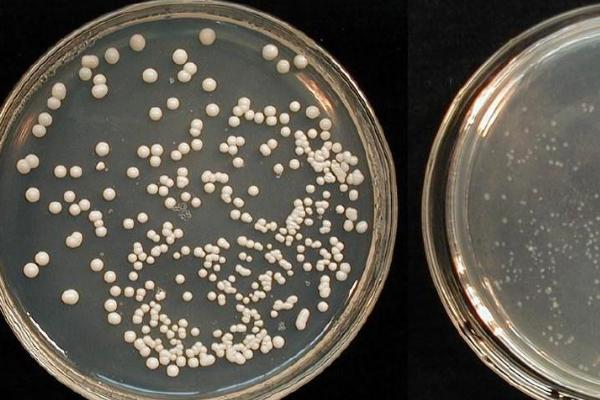
菌种选育的优缺点,可以纯化菌种但工作量大
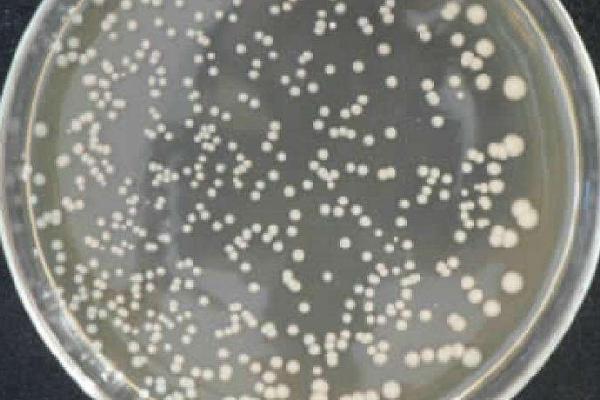
菌种选育的优缺点,可以纯化菌种但工作量大

自然选育:优点是操作方便,可纯化菌种,避免菌种衰退,还能提高产量,确保生产稳定性。缺点是工作量大,进展慢,效率低,自然突变的几率不高,难以筛选出理想的菌株。
诱变育种:优点是具有较高的突变率,缺点是遗传性质不稳定。
一、菌种选育的优缺点
1、自然选育
(1)优点:方便操作,而且可以纯化菌种,防止菌种衰退,确保生产的稳定性,通常也可以提高产量。
(2)缺点:工作量大,效率比较低,而且进展也比较慢,自然突变的机率比较小,通常比较难筛选到理想的菌株。
2、诱变育种
(1)优点:突变率一般比较高。
(2)缺点:遗传性质不太稳定。
3、杂交育种
(1)优点:将同一个物种里的2个或者多个优良性状集中在一个新品种中,一般可以产生杂种优势,从而获得比亲本品种更强,或者表现更好的新品种。
(2)缺点:育种的过程比较缓慢,而且过程也比较复杂。

二、菌种保藏的原理
1、菌种保藏的原理主要是人为创造条件尽可能降低生物体内的代谢活动,以达到延长生命、减少变异的目的。
2、其中低温、干燥和隔绝空气是使微生物代谢能力降低的重要因素。